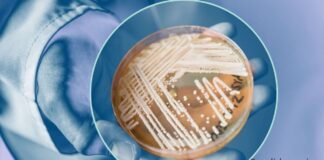
Funghi e Malattie

Tag: antonio marsilio
Il Latte Umano
Scienze - I suoi superiori risultati sulla salute del neonato rispetto al latte artificiale stanno indirizzando la ricerca medica e l’interesse dell’industria del settore su...
Funghi e Malattie
Scienze -
Le naturali difese immunitarie dei mammiferi contro le micosi non reggono all’impatto dei cambiamenti ambientali in corso.
Di Antonio Marsilio Modena, 11 marzo 2024 -...